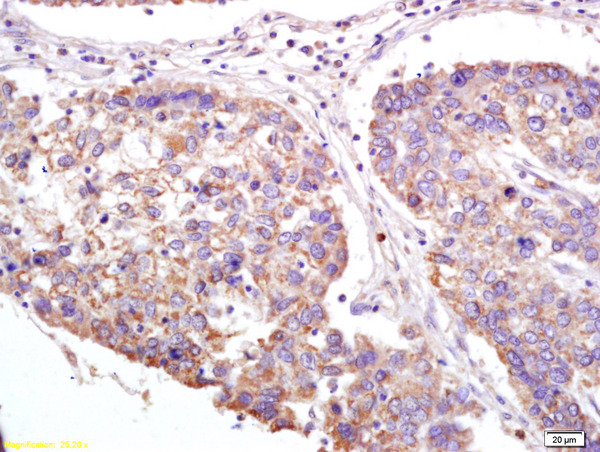
Formalin-fixed and paraffin embedded human lung carcinoma labeled with Anti-XAGE2 Polyclonal Antibody, Unconjugated (bs-7017R) at 1:200 followed by conjugation to the secondary antibody and DAB staining. Formalin-fixed and paraffin embedded human lung carcinoma labeled with Anti-XAGE2 Polyclonal Antibody, Unconjugated (bs-7017R) at 1:200 followed by conjugation to the secondary antibody and DAB staining.

Formalin-fixed and paraffin embedded human colon carcinoma labeled with Anti-XAGE2 Polyclonal Antibody, Unconjugated (bs-7017R) at 1:200 followed by conjugation to the secondary antibody and DAB staining.
XAGE2 Polyclonal Antibody
BS-7017R
ApplicationsImmunoFluorescence, Western Blot, ELISA, ImmunoCytoChemistry, ImmunoHistoChemistry, ImmunoHistoChemistry Frozen, ImmunoHistoChemistry Paraffin
Product group Antibodies
ReactivityHuman
TargetXAGE2
Overview
- SupplierBioss
- Product NameXAGE2 Polyclonal Antibody
- Delivery Days Customer16
- ApplicationsImmunoFluorescence, Western Blot, ELISA, ImmunoCytoChemistry, ImmunoHistoChemistry, ImmunoHistoChemistry Frozen, ImmunoHistoChemistry Paraffin
- Applications SupplierWB(1:300-5000), ELISA(1:500-1000), IHC-P(1:200-400), IHC-F(1:100-500), IF(IHC-P)(1:50-200), IF(IHC-F)(1:50-200), IF(ICC)(1:50-200)
- CertificationResearch Use Only
- ClonalityPolyclonal
- Concentration1 ug/ul
- ConjugateUnconjugated
- Gene ID9502
- Target nameXAGE2
- Target descriptionX antigen family member 2
- Target synonymsCT12.2, GAGED3, XAGE-2, XAGE2B, X antigen family member 2, G antigen family D member 3, X antigen family, member 2B, cancer/testis antigen 12.2, cancer/testis antigen family 12, member 2
- HostRabbit
- IsotypeIgG
- Protein IDQ96GT9
- Protein NameX antigen family member 2
- ReactivityHuman
- Storage Instruction-20°C
- UNSPSC41116161